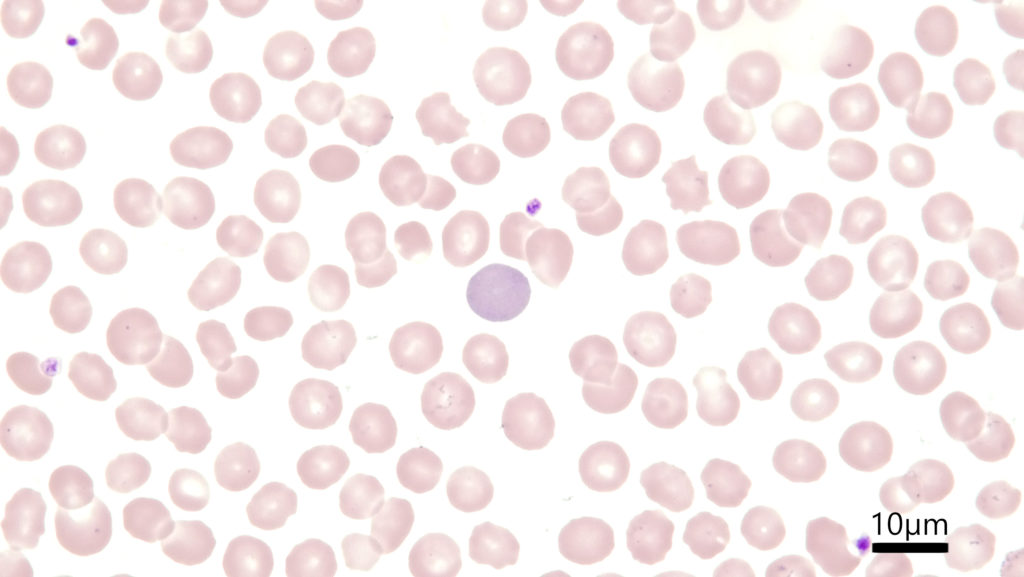
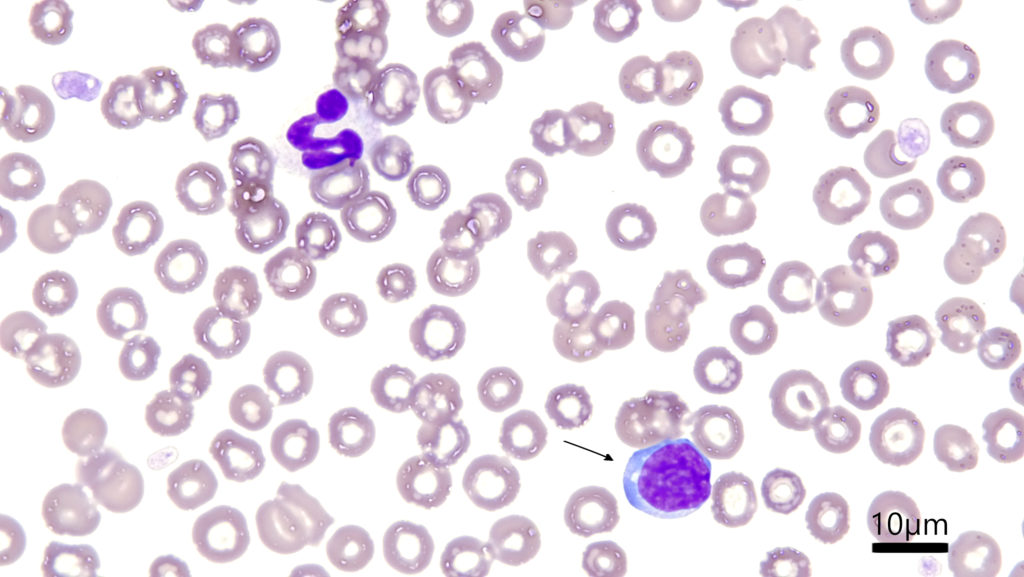
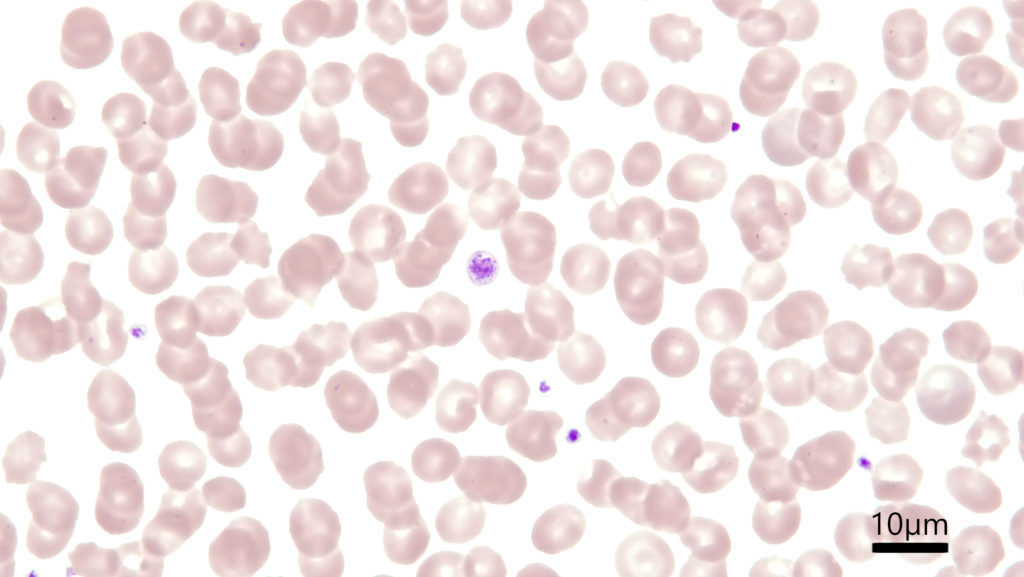
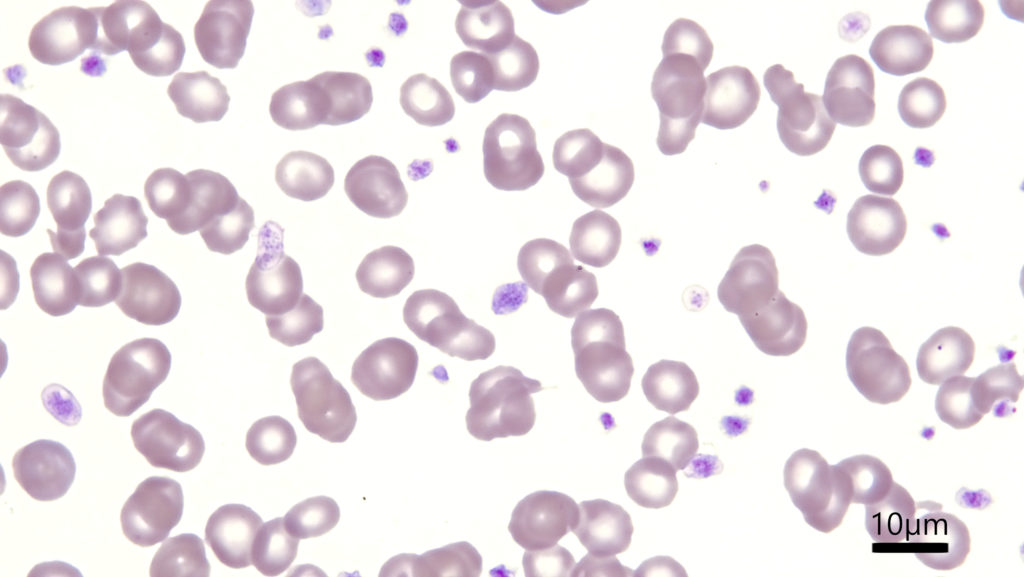

顕微鏡写真: ライト・ギムザ染色
去年の11月にDiff-Quik染色についての記事を書きましたが、ライト・ギムザ染色との見え方の違いが比較しづらいかなと思い、今回は過去に掲載済みの写真も含めてライト・ギムザ染色とDiff-Quik染色の写真を色々比較してみることにしました。さっそく写真をご覧ください。
まずは赤血球。

続いて好中球。


リンパ球。

血小板。

とりあえず今日のところは以上です。やはりライト・ギムザ染色の方が染まりあがりが繊細ですね。でも今回お示しした写真においては、リンパ球の核の染まり方や血小板の顆粒の染色性は意外とどちらもあまり大差ないように見えます。こうやって二枚を比較しながらみたことがなかったので、我ながら面白いですね。今度幼若細胞の核の染色性の違いがどう見えるのか、写真が撮り溜まったらまた第二弾をやってみたいと思います。いつになるか分かりませんが乞うご期待です。


